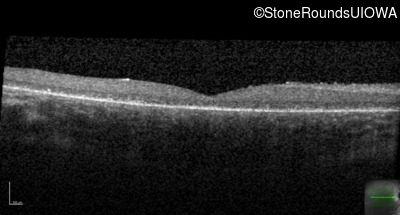
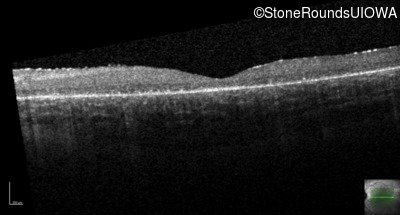
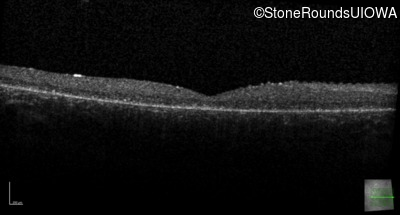
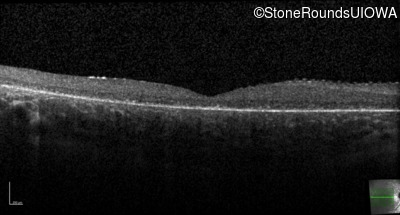
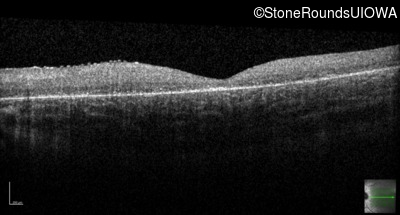
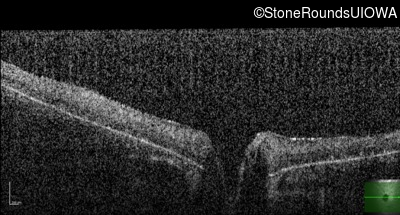

Case
SR74
Student Mode
Batten Disease (IB3)
Male
Male
Hidden
SR74
Student Mode
Batten Disease (IB3)
Male
Male
History
This 7 year old boy's mother first noticed that he was tripping over objects in dim light about one year ago.
| Age at visit: 7 years |
| Age at visit: 9 years |
| Age at visit: 11 years |
Diagnosis & molecular findings
| Disease | Gene | Allele 1 variant(s) | Allele 2 variant(s) | Inheritance mode |
|---|---|---|---|---|
| Batten Disease | PPT1 | Thr75Pro ACC>CCC | IVS6-1 G>T | AR |